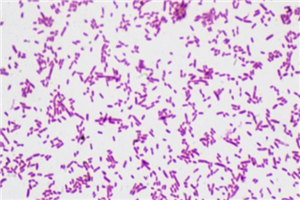

胃癌不会传染?但这种“致癌菌”,1人感染全家都有危险
来源:医联媒体
众所周知,胃癌是比较常见的消化道恶性肿瘤,这种消化道恶性肿瘤在发病过程中会引发各种不良症状。因此,留意到胃癌的苗头,应该第一时间展开治疗,通过合理的方式控制病情发展,这样才能防止胃部的癌变严重。
另外,引发胃癌的原因多种多样,需要了解具体的疾病源头,从根本上进行预防,这样才能防止胃癌发病率增高。那么,查出哪种菌,全家都可能会感染,患上胃癌的可能性会明显升高呢?
胃癌的发病率之所以比较高,主要和胃癌的诱发原因多种多样有关。其中,感染了幽门螺旋杆菌,患上胃癌的可能性也会明显增高。幽门螺旋杆菌是一种螺旋形,微厌氧,可以在人体胃部寄生的细菌。
这种病菌入侵之后会对胃部功能造成影响,比较常见的就是出现慢性胃炎,胃溃疡。这些疾病都可能是幽门螺旋杆菌感染引起,而在幽门螺旋杆菌持续感染的情况下就容易增加癌症的患病风险,这也是胃癌发病率较高的原因。而感染了这种幽门螺旋杆菌,全家受到感染的概率也比较高,因此需要积极预防,防止胃癌出现。

感染了幽门螺旋杆菌,会有哪些不良反应?
1、胃痛
感染幽门螺旋杆菌身体发出的信号是比较明显的,如果经常有胃痛这种现象产生,有可能是幽门螺旋杆菌入侵引起。因为这种病菌入侵之后比较容易导致胃部发生溃疡,甚至会有感染的现象,常见的感觉就是胃部产生疼痛感。
如果已经有这种现象产生,说明胃癌可能出现,需要针对幽门螺旋杆菌感染的现象采取治疗措施,这样才能防止幽门螺旋杆菌持续入侵威胁健康。
2、便血
在幽门螺旋杆菌入侵身体的时候,可能会有便血这种情况发生。因为部分人幽门螺旋杆菌持续感染,局部出现溃疡,甚至已经有恶性肿瘤出现,此时消化道黏膜受损,加上肿瘤本身破裂出血,都可能会导致粪便中含有的铁元素量增多,因此更容易有便血的现象。

如果已经出现了这种情况,说明胃癌可能找上门来,需要通过合理的方式控制病情发展。只有胃部的癌变得到控制,便血这种情况才能改善。
由此可见,幽门螺旋杆菌的入侵会对人体健康造成威胁,这种病菌持续感染,很容易导致胃癌的患病率增高。为了有效预防胃癌,最重要的就是积极预防幽门螺旋杆菌,一旦有幽门螺旋杆菌入侵的信号,也要及时治疗,防止胃部病变出现。
收藏
回复(1)参与评论
评论列表
























